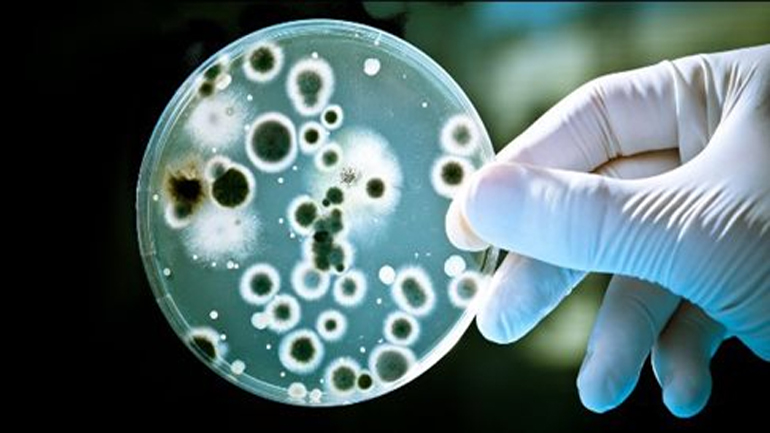
Ανακαλύφθηκαν βακτήρια ανθεκτικά και στα πιο ισχυρά αντιβιοτικά

Τρισδιάστατος εκτυπωτής που χρησιμοποιεί μελάνι από βακτήρια για να παράγει «ζωντανά» υλικά
Η πρόοδος στους τρισδιάστατους εκτυπωτές είναι συνεχής και σε λίγα χρόνια μάλλον δεν θα υπάρχει σχεδόν τίποτε που να μη μπορεί να παραχθεί από μια τέτοια συσκευή...
04/12/2017 | 19:15

.jpg)